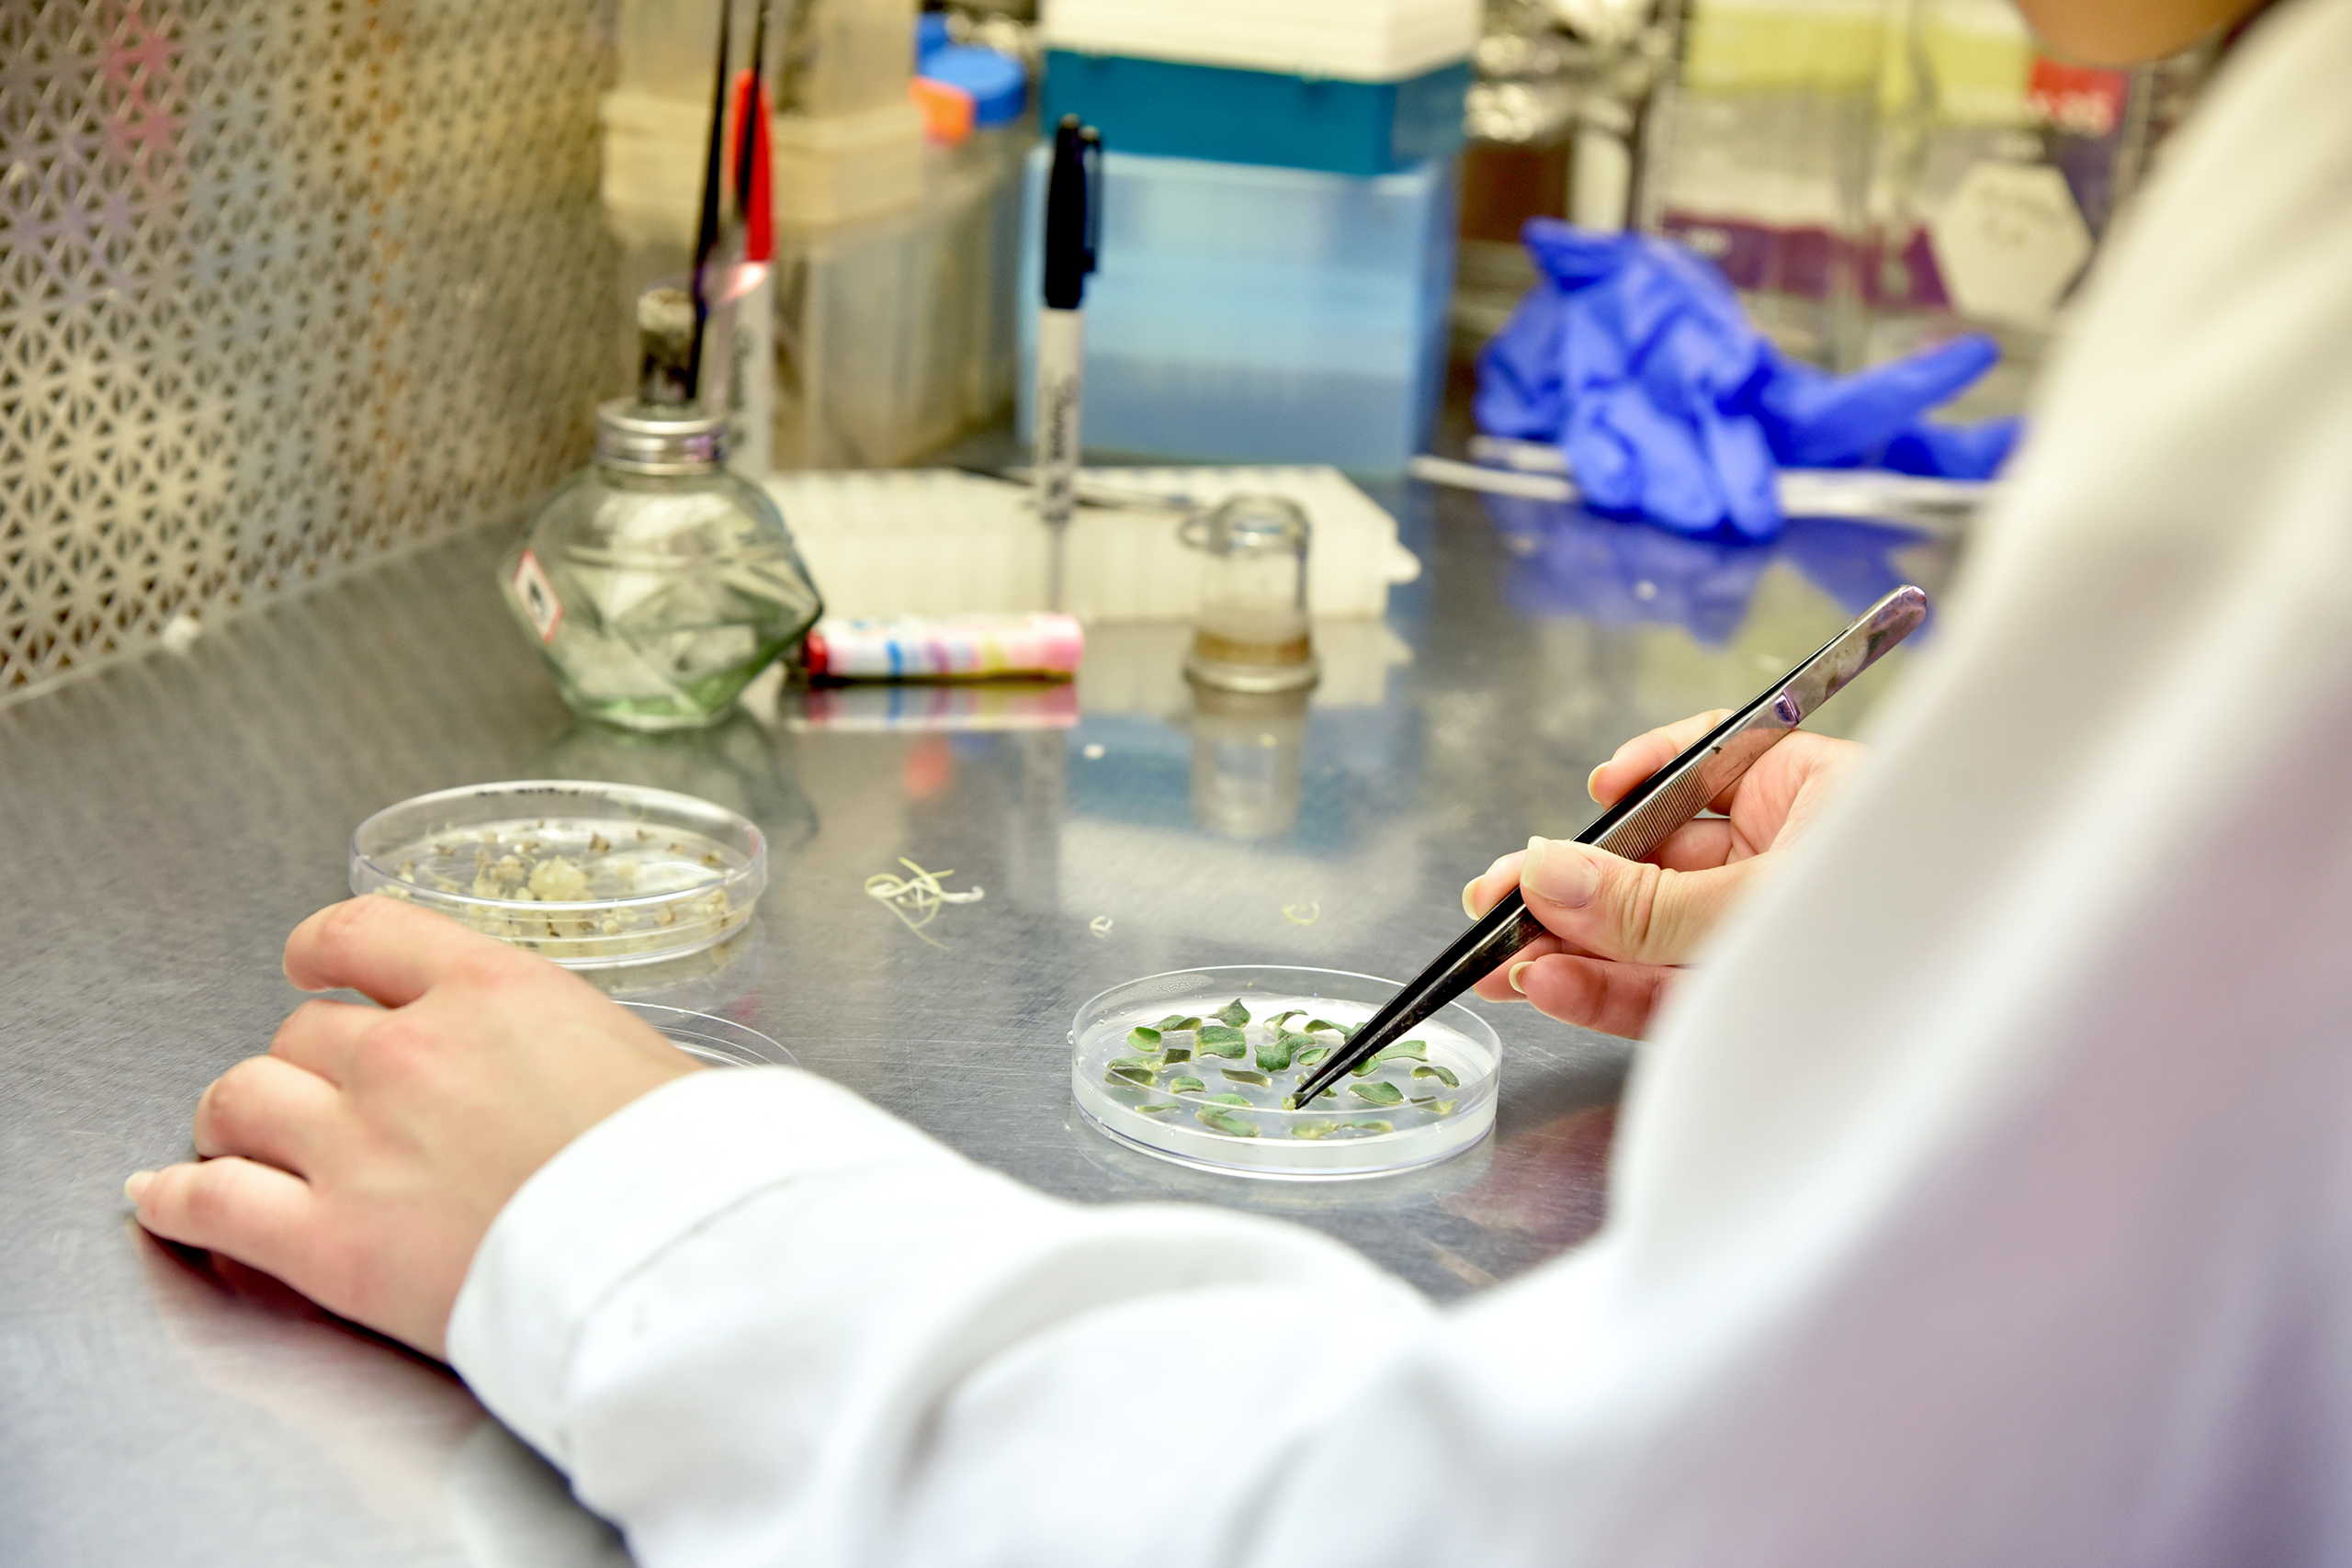
reseacher using tweezers on plants in a petri dish

Ph.D. in Plant Science
The Department of Plant Science and Landscape Architecture welcomes motivated Ph.D. students from around the world to explore their interests and develop skills to propel them into fulfilling careers, from academia to research and industry.

Program Overview
At UConn, the Department of Plant Science and Landscape Architecture offers graduate education that reflects the depth and diversity of our faculty’s research expertise. Students pursuing the Doctor of Philosophy (Ph.D.) degrees can specialize in areas such as:
- Agronomy
- Horticulture
- Landscape Architecture
- Plant Biotechnology
- Plant Breeding
- Plant Environment
- Plant Health
- Soil Science
Graduate students work closely with a faculty advisor to design a personalized plan of study that integrates advanced coursework, research, and professional development. Each program is tailored to align with the student’s interests and career goals while fulfilling the degree requirements outlined below.
Degree Requirements
To earn a Ph.D. in Plant Science, students must complete the following requirements.
Courses
UConn Requirements. For UConn requirements, visit the Registrar’s Steps to a Successful Graduation Website and UConn Catalog.
Department Requirements. The suggested courses should provide the best training for future needs and are tailored to the student’s individual goals. The coursework shall consist largely of courses at the 5000 level or above. A limited number of credits at the 3000 or 4000 levels (not more than six) may be included in a graduate degree plan of study. Undergraduate (below 5000-level courses) are applicable only if required by the Advisory Committee. The Ph.D. in Plant Science does not have a related area or foreign language requirement. Credit hours may vary and should be discussed with the Major Advisor.
A related area must comprise a coherent unit of at least six credit hours of advanced work outside the field of study (or area of concentration) and usually outside the Department.
Students are required to enroll in two semesters of the seminar course PLSC 5897. One poster or oral presentation at a national or international professional meeting in your field of study may substitute for one PLSC 5897 seminar course requirement for Ph.D. degrees. Students who completed their Master of Science in our department may enroll in one semester of PLSC 5897 and present at a professional meeting.
General Ph.D. Examination
UConn Requirements. For UConn requirements, visit the Registrar’s Steps to a Successful Graduation Website and UConn Catalog.
Department Requirements. Students should discuss examination expectations of each member of the Advisory Committee a few months in advance of the General Examination and ask about the exam format and the topics to be covered.
No fewer than five faculty members, including all members of the student’s Advisory Committee, must participate in the examination, and all members of the Advisory Committee must participate in any oral examination. Some members of the Advisory Committee may participate remotely via videoconference in the oral portion of the General Examination. The Examining Committee includes at least one faculty member representing each of the major areas addressed in the examination. All Examiners are invited to submit questions and to evaluate answers, but the final decision as to whether or not the student has passed the General Examination shall rest solely with the Advisory Committee.
If the student does not pass any of the exams given by the Advisory Committee members, then the student may retake any failed portions of the exams. The number of times this exam can be retaken is decided by the Advisory Committee members, although twice is the common limit.
The General Examination consists of written and oral portions of the exam, which cannot be the same as the dissertation or portions thereof:
Written Portion. Coordinated by the Major Advisor. Advisory Committee members prepare and grade their own questions. They each also specify the time allowed to answer their questions and allowed materials (e.g., 2-hour limit, closed book, closed internet, SAS software allowed).
Oral Portion. Should be comprehensive in scope. A minimum of 2-hours should be scheduled, though there is no time limit. The oral exam or field exam is given by the Examining Committee members. If desired, the student’s Advisory Committee can request that this oral exam be combined with the written exam noted above, i.e., the oral exam can be a follow-up to the written exam described above and is often used for clarification of marginally written answers, rather than having any student fail outright.
Dissertation and Oral Defense (Final Examination)
For UConn dissertation information and requirements, visit the Registrar’s Steps to a Successful Graduation Website and the UConn Catalog.
Department Requirements.
Students are expected to publish their research findings. Publications will improve your chances to find a job and enhance the reputation of our department. Publishing is important for the broader dissemination of your work, as many people will read publications in professional journals. It is recommended to organize your Dissertation accordingly to allow for easy formatting of the chapters into manuscripts. Conversely, if manuscripts are already published, they become your chapters. Discuss the Dissertation structure with your Major Advisor at the beginning of your graduate study.
Teaching Requirement. Teaching experience is not required by the department. However, for those students who are interested in careers in academia, opportunities exist to gain teaching experience by working as a teaching assistant or helping various faculty with extension projects.
Foreign Language Requirement. The PhD in Plant Science does not have a related area or foreign language requirement.
Timeline
Year 1
- Start research project
- Enroll in coursework
- Choose Advisory Committee members
Year 2
- Continue research project
- Enroll in PLSC 5897
- Complete coursework
Year 3
- Submit Plan of Study to the Graduate School
- Pass Ph.D. General Examination
- Complete the departmental review of the Dissertation Proposal
Preparing to Graduate
Admissions
Applicants should refer to the Graduate School for deadlines.
More Information
Questions?
For more information about the MS or Ph.D. programs in Plant Science, please contact Haiying Tao.